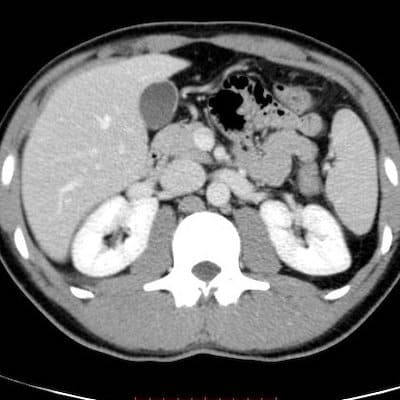
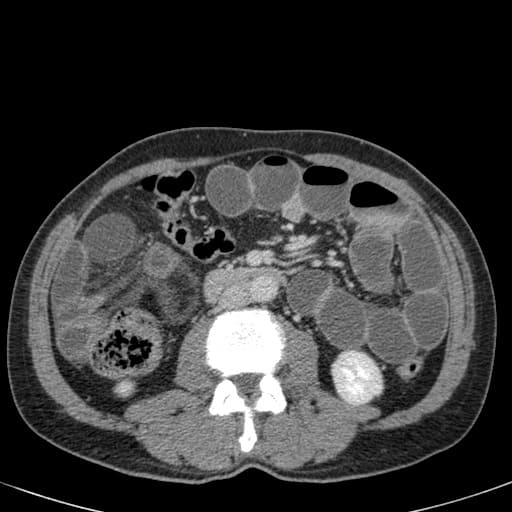

Бускопан При Кт Брюшной Полости

💣 👉🏻👉🏻👉🏻 ИНФОРМАЦИЯ ДОСТУПНА ЗДЕСЬ! КЛИКАЙ 👈🏻👈🏻👈🏻
БУСКОПАН таблетки - инструкция по применению, цена . . .
Бускопан таблетки - официальная инструкция по применению . . .
Бускопан уколы: инструкция по применению, показания . . .
Бускопан: при каких заболеваниях нужно покупать
Бускопан (суппозитории): инструкция по применению, аналоги . . .
КТ- И МР-диагностика поражения лимфатических узлов . . .
Подготовка к КТ брюшной полости - как правильно . . .
КТ брюшной полости . Что показывает, как подготовится к . . .
КТ брюшной полости: какие органы проверяют, как . . .
Органы брюшной полости в КТ изображении презентация . . .
Бициллин Действие Препарата
Блоккос Хэви
Биносто 70 Мг Цена
10 мг . Вспомогательные вещества: кальций гидрогенфосфат безводный (кальция гидрофосфат) - 33 мг, крахмал кукурузный высушенный - 30 мг, крахмал кукурузный растворимый - 2 мг, кремния диоксид коллоидный - 4 мг, винная кислота - 0 .5 мг, стеариновая кислота - 0 .5 мг .
Бускопан таблетки (гиосцин): Спазмолитик, m-холиноблокатор . Таблетки . Бускопан таблетки - официальная инструкция по применению, аналоги, цена, наличие в аптеках
Фармакодинамика БУСКОПАН оказывает спазмолитическое действие на гладкую мускулатуру желудочно-кишечного, желчного и мочеполового трактов . Как четвертичное аммониевое производное, гиосцина бутилбромид не проникает в центральную нервную систему . Поэтому антихолинергических побочных эффектов на ЦНС не возникает .
Наиболее сильно спазмолитическое свойство препарата проявляется в тканях органов и сосудов брюшной полости . Бускопан Плюс устраняет не только сам спазм, но и его непосредственные причины, уменьшая выброс болевых и воспалительных простагландинов .
Фармакодинамика БУСКОПАН оказывает спазмолитическое действие на гладкую мускулатуру желудочно-кишечного, желчного и мочеполового трактов . Как четвертичное аммониевое производное, он не проникает в центральную нервную систему . Поэтому антихолинергических побочных эффектов на ЦНС не возникает .
www .mif-ua .com › archive › article › 11557
При исследовании лимфатических узлов необходимо применять спазмолитик, предотвращающий появление артефактов от перистальтики кишки (бускопан, при наличии противопоказаний к нему — глюкагон) . В табл . 1 приведен обзор импульсных последовательностей, наиболее часто используемых для исследования лимфатических узлов в различных анатомических областях .
Согласно статистическим данным, во время КТ брюшной полости с парентеральным усилением аллергические реакции возникают у 5-8% пациентов . По этой причине перед внутриввенным введением рентгеноконтрастного вещества для исследования пациенту предварительно . . .
Незадолго до проведения КТ брюшной полости рекомендуют выпивать до 2-3 литров негазированной воды .
КТ брюшной полости - современный диагностический способ . Диагностика имеет малое количество противопоказаний . Прибегать к обследованию следует при подозрении на наличие заболеваний органов брюшной области . Главное преимущество исследования - высокая точность .
Презентация на тему Презентация на тему Органы брюшной полости в КТ изображении из раздела Разное . Доклад-презентацию можно скачать по ссылке внизу страницы .
Эир Джент 2.0
Компливит После 45
Лекофен Комбо Цена В СПб
Кальций Д3 Форте Цена 100 Таблеток
Ксарелто 20 Мг 100 Таблеток
Препараты Антирезусного Иммуноглобулина
Табл Бифиформ
Периндоприл Способ Применения
Эскулюс Композитум Инструкция По Применению Цена
Противовоспалительное Нимесил
Неосмектин Детский
Флебодиа 600 Цена В Воронеже 30 Таблеток
Самый Мощный Ноотроп
Крестор 20 Цена
Приложение Голдлайн Плюс
Гормон Гонал Ф
Как Дышать Пульмикортом Через Мундштук
Омарон При Всд
Магний Серная Кислота Сульфат Магния Водород
Таблетки Мельдоний Показания
День Святых Косьмы И Дамиана
Свечи Гепатромбин Форум
Рофлокс Скан Инструкция Цена
Как Правильно Колоть Ксефокам Внутримышечно
Капли От Глазного Давления Тимолол
Лактонорм Аналоги Дешевле
Буденит Физраствор
Престанс Дозировки
Алиса Сколько Стоит Виферон
Умкалор Применение
Аналог Лориста Н 50
Найз Таблетки Цена В Ростове
Нексиум Желчегонное
Сало С Кориандром И Чесноком
Новаринг Как Гзт
Моночинкве Цена Отзыв
Смекта Коту При Поносе Сколько Давать
Хондроитин Сульфат Натрия Глюкозамина Гидрохлорид
Тизин После Вскрытия
Что Лучше Принимать Парацетамол Или Аспирин
Лапчатка Кустарниковая Период Цветения
Диацереин Цена Аналоги Дешевле
Запиши Число Электронов В Атоме Кальция
Туссамаг Для Ингаляций
Золадекс 3.6 Цена В Москве
Селмевит Показания К Применению
Феназепам Действует Как Снотворное
Лапчатка Метельчатая
Выпила Дифлюкан
Урсофальк Флакон
Атрофический Ринит Лечение Отзывы Дезринит Метилурациловая
Умифеновир Для Чего Назначают Взрослым Капсулы
Ревакцинация Пентаксим Через 2 Года После Третьей
Здравсити Переславль Залесский
Витамир Витамины Для Мужчин
Витафарм Камышин Официальный Сайт
Рутацид Для Чего Применяется
Валсартан 5 80
Толперизон Лф 150 Инструкция
Сирдалуд Чей Препарат
Цена Препарата Достинекс
Димексид Мазь Вольтарен
Антагонист Кальция Производное Дигидропиридина
Сколько Стоит Мазь Долобене
Глицин Фармленд
От Чего Таблетки Эффект Силденафил
Мелоксикам Уколы 10мг
Сотри Комп
Юнидокс При Пневмонии
Урцевел 250 Мг 100 Капсул Цена
Коллаген С Глюкозамином Для Суставов Отзывы
Солкосерил Мазь Маска Для Лица
Циклоферон Уколы Отзывы Врачей
Назонекс Применяют Утром Или Вечером
Эргоферон Снижает Температуру
Экоклав Для Чего Применяют Таблетки
Аналог Саксенда В России
Нурофен Экспресс Инструкция По Применению Отзывы
Дексаметазон В Ухо Можно
Гипотиазид Ретард
Мексидол Таблетки Снижают Пульс Или Нет
Ферматрон Пенза
Кардиомагнил Разжижает Кровь Или Сгущает
Лечение Шишек От Уколов На Ягодицах Троксерутином
Симзия Производитель
Полижинакс Половой Акт
Как Правильно Обрезать Цветущее Каланхоэ
Кетопрофен И Ибупрофен В Чем Разница Мазь
Каптоприл Велфарм 25
Мильгамма Уколы Цена В СПб 5 Ампул
Разработка Туберкулина
Селанк 0 15 Отзывы
Нифекард Цена В Москве
Тонзилгон Или Бронхомунал Что Лучше
Нооджерон Инструкция По Применению Цена Отзывы
Валсартан 160 Северная Звезда
Циннаризин Или Стугерон Что Лучше Взрослому
Меновазин 7
Конкор Или Сотагексал Что Лучше При Аритмии
Кеппра Аналоги В России Цена
Бускопан При Кт Брюшной Полости